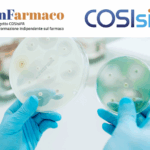

La Giunta regionale della Lombardia, su proposta dell’assessore al Welfare, Guido Bertolaso, ha approvato il progetto che segna l’avvio della collaborazione tra Regione e Repubblica dell’Uzbekistan per la formazione e l’inserimento di personale infermieristico.
A ottobre 2025 arriveranno in Lombardia i primi dieci infermieri dall’Uzbekistan, accolti dal project coordinator dell’Agenzia della Migrazione del Governo uzbeko. Si tratta della fase iniziale di un programma di cooperazione sanitaria che prevede percorsi di formazione clinica e teorica nell’Asst Fatebenefratelli-Sacco di Milano, con l’obiettivo di rafforzare gli scambi formativi e professionali tra i due Paesi, avviati nel giugno 2025 con una visita in Uzbekistan del presidente di Regione Lombardia, Attilio Fontana, e di dirigenti regionali della Direzione Welfare.
Durante il periodo di soggiorno, della durata di circa tre mesi, gli operatori saranno impegnati in un percorso formativo che comprende attività in diversi reparti ospedalieri, tra cui pronto soccorso, terapia intensiva, cardiologia, nefrologia, oncologia e area pediatrica, con la supervisione di tutor infermieristici e mediatori linguistici.
Regione Lombardia fa sapere che l’iniziativa rappresenta il primo passo di un accordo più ampio, che prevede entro la fine del 2025 l’apertura di una unità di missione di coordinamento a Tashkent, capitale dell’Uzbekistan, per seguire lo sviluppo dei successivi programmi di cooperazione tra le università mediche lombarde e uzbeke.
Da novembre 2025 partiranno inoltre i corsi di lingua italiana per 150 infermieri a Tashkent e 60 a Samarcanda, in preparazione alla successiva fase di reclutamento prevista per il 2026. L’obiettivo è far arrivare in Lombardia i 210 infermieri all’inizio del 2026.
“Questo progetto – sottolinea l’assessore Guido Bertolaso – è un modello di cooperazione internazionale che unisce formazione, competenze e solidarietà. L’obiettivo è creare scambi stabili tra lombardia e Uzbekistan per formare professionisti capaci di rispondere ai bisogni della nostra sanità e, al tempo stesso, valorizzare le esperienze di crescita nei Paesi partner”.
Redazione Nurse Times
Fonte: Regione Lombardia
Articoli correlati
- Lombardia, Bertolaso importa 500 infermieri da Argentina e Paraguay
- Bertolaso: “Carenza di infermieri in Lombardia? Li cercheremo all’estero”
- Bertolaso insiste e rilancia: “Infermieri sudamericani in Lombardia entro fine anno. Cercheremo anche tecnici e medici”
Unisciti a noi su Telegram https://t.me/NurseTimes_Channel
Scopri come guadagnare pubblicando la tua tesi di laurea su NurseTimes
Il progetto NEXT si rinnova e diventa NEXT 2.0: pubblichiamo i questionari e le vostre tesi
Carica la tua tesi di laurea: tesi.nursetimes.org
Carica il tuo questionario: https://tesi.nursetimes.org/questionari

Lascia un commento